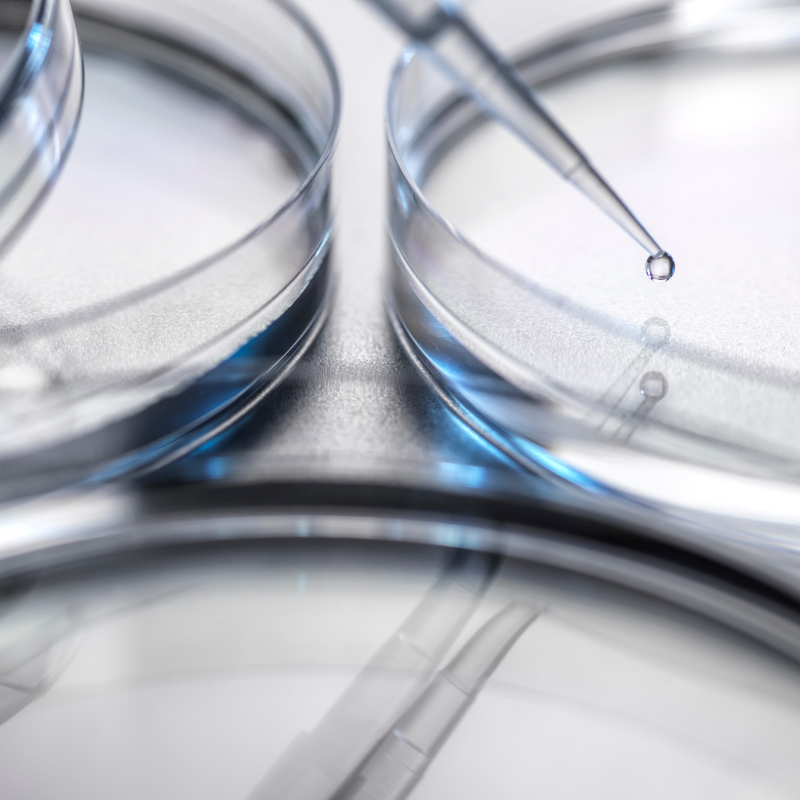
줄기세포 이미지

본문콘텐츠영역
The optimal balance of beauty
that begins with understanding my body
내 몸에 대한 이해부터 시작되는
최적의 아름다움 밸런스
Cellting Inner Balance
셀팅만의 Inner
밸런스 검진 시스템
-

몸을 이해해야,
최적의 아름다움을
완성할 수 있습니다셀팅의 이너밸런스 검진 시스템은 줄기세포 정맥주사의 효과를 극대화하기 위해 설계된 정밀한 사전 검사 프로그램입니다. 호르몬, 활성산소, 유전자, 텔로미어 등 체내 상태를 종합적으로 점검하여 개인별로 최적화된 치료 플랜을 제공합니다. 검사 항목은 단순한 진단을 넘어, 신체의 노화 정도와 건강 상태를 세부적으로 파악하고, 이를 바탕으로 줄기세포 정맥주사와 일반 리프팅 및 피부 시술(익스뷰티)을 결합한 융합 치료를 통해 내면과 외면의 아름다움을 완성합니다.
Inner Balance Program
Inner 밸런스
검진 프로그램
줄기세포 정맥주사
- 호르몬 및 채혈검사
- 활성산소 검사
- 유전자 검사
- 텔로미어 검사
- 폐기능 검사
- 생활습관 조사
Cellting Inner Beauty
셀팅 Inner 뷰티 효과
줄기세포 정맥주사
- 전신 세포 재생과 회복
- 생활 에너지 활력 증대
- 피부 톤 & 피부결 개선
- 피부 톤 & 피부결 개선
- 노화 방지 슬로우 에이징
- 혈관 건강 증진
- 면역력 강화 염증 완화
셀팅에서 만나는
진정한 뉴에이징
-
Inner
Beauty내면의 아름다움
-
Ex
Beauty외면의 아름다움
셀팅 줄기세포 연구소
셀팅의원 줄기세포 연구소는 노바스템 줄기세포 기술을 기반으로 줄기세포의 가능성을 탐구하며, 이너뷰티와 익스뷰티의 융합을 통한 최적의 시술을 제공하기 위해 노력합니다